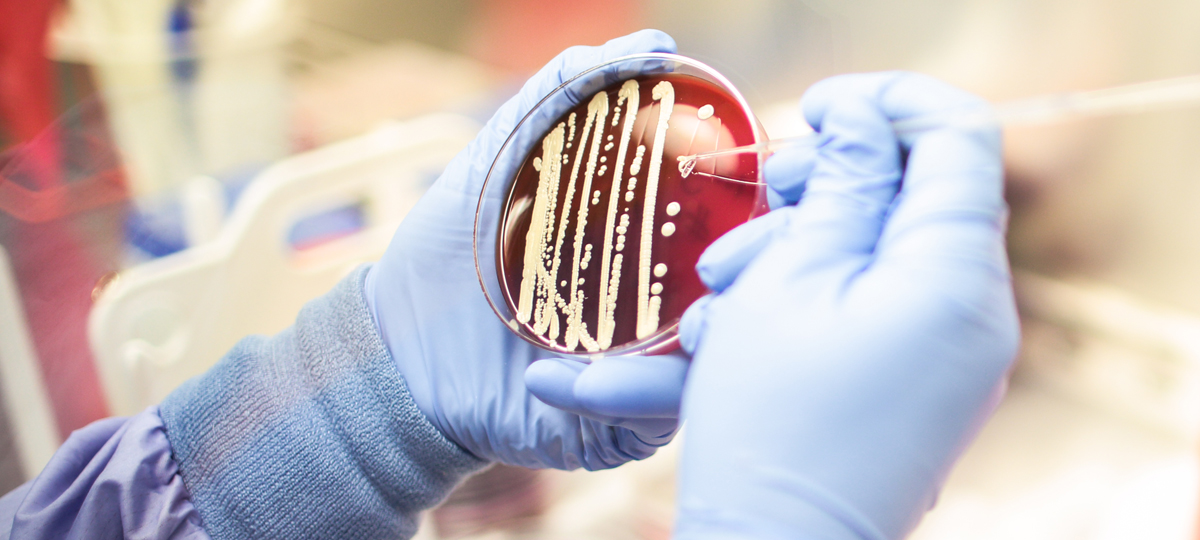

Microbial Solutions
|
Hayden Skalski
Pharma 4.0
Why pharmaceutical manufacturers require modern QC Micro technologies
In just a decade, technology has made advances thought only possible in science fiction and futuristic movies. The cell phone, for example, has evolved from a simple device that makes calls, into a personal assistant that can capture every special moment, make a single purchase with a fingerprint, monitor your heart rate, and even control the temperature in your home.
We have quickly embraced and adapted to these advances and now expect real-time communication, instantaneous news alerts, and reminders to stay healthy. Keeping pace with innovations and embracing advice on industry hot topics and trends through knowledgeable thought leaders and society influencers keeps us current. The cell phone is only one of many leaps in technology that has impacted most of our global population.
Industry-specific developments have been available and positively impacting global pharmaceutical manufacturers over the last ten years, but has industry embraced and implemented these progressive technologies and shifts towards automation, the way society has with the cell phone?
Within the last ten years, we have experienced systems, processes, and devices that have become more efficient, versatile, portable, and rapid. These iterations are typically next generations of the originals, but the technology boasts improvements and upgrades to stay current with our expectations and updated requirements. In defining “cGMP,” a standard and term commonly used in pharmaceutical processes, the ‘C’ stands for “current”. The ‘C’ was added to Good Manufacturing Practices (GMP) to remind organizations that they need to remain up to date with the latest technology.
So, are all pharmaceutical manufacturers “current”?
It can be a struggle for pharma manufacturing to implement necessary change. The fear of change and risk when implementing new technologies to optimize processes and improve quality and speed of production can be mitigated and supported when partnering with companies that confidently sustain and support their technology. With advancements in technology, it is important to seek out new systems and methods that deliver advantages in lab efficiency and operations. It is essential to implement technologies that is not only well supported by the manufacturer but fits most product testing requirements. A core focus when implementing new technology is to provide thorough training, ensuring that internal laboratory personnel are aware and capable to implement effective changes and more importantly, they understand the value.
High product quality is the thing
Regulations and guidance require manufacturers to have controlled processes to ensure high product quality that is both safe and effective. Along with product quality and safety, production speed – from raw material to delivery – is a critical aspect. Bacterial endotoxin testing (BET) is a required safety test by all pharmaceutical manufacturers for all raw materials, finished product, and water for injection (WFI) for product lot release. Over the last 40 years, manufacturers have been using the gold standard for endotoxin testing, the Limulus amoebocyte lysate test (LAL) test. Following traditional kinetic or gel-clot methods, FDA-licensed cartridge technology has become widely popular over the last 14 years as a compendial, rapid endotoxin testing method. Although traditional test methods confirm safety and efficacy during manufacturing processes and have proven to be valid and effective for many years, they are manual, subjective, expensive, time consuming, require large volumes of LAL reagents, and take far too long to yield results – which in time could pose a threat to product quality.
These traditional methods could also be posing a risk to data integrity. One key influence is the general shift by industry from paper-based systems to fully integrated electronic data collection platforms with traceability from raw material to QC laboratory to final finished product. This shift has changed the way we operate in the industry and has allowed for great improvements in product quality, manufacturing capacity, and organizational efficiency.
Data integrity essential
Organizations are being challenged not only on product quality, but how they approach the protection and security of the data that is collected. One of the best considerations is to mitigate the risk for human error, moving towards automated methods rather than manual traditional methods. FDA-licensed cartridge technology provides the automated science and tools necessary to confirm the processes and products are free from microbial contamination, with many added benefits over traditional microbiology methods. Shifting to cartridge-based technology yields objective results, removing the possibility of human error. In addition to eliminating a significant amount of LAL reagents, raw materials, and accessories that are required for traditional methods, cartridge technology also reduces time-consuming preparation and long turnaround times to result.
Just as society continues to embrace and adapt to advances in technology with personal devices, the adoption of laboratory system advances and shifts towards automation should be considered by pharmaceutical manufacturing scientists and quality control professionals. Implementing laboratory and manufacturing automation, as well as rapid test methods, such as BET cartridge technology and rapid microbial detection methods (RMMs), helps the biotech field comply with Pharma 4.0, which focuses on the concepts of increased automation and improved communication between machines, as well as machines that analyze data with little to no human interaction. Rapid BET and RMMs increases data integrity, mitigates risk, and saves significant time and money.
In conclusion
As Pharma 4.0 continues to highlight on automation, it fits extraordinarily well with the advanced technology of our modern manufacturing world. Having knowledge and understanding of these rapid technologies, and what core requirements are suggested to implement new processes, will significantly improve and influence laboratory decisions and produce quality-compliant results with confidence. Moving towards implementing automated microbiology and advanced rapid technology is not the way of the future, it is a current, compliant, and a cost-effective way to enhance and improve laboratory processes, product quality, safety, and data integrity. We embrace new concepts and technologies in our personal lives every day to make things easier, simpler and more efficient. Why not continue that mindset in our careers and work smarter, not harder?
Check out our portfolio of QC Microbial Solutions
